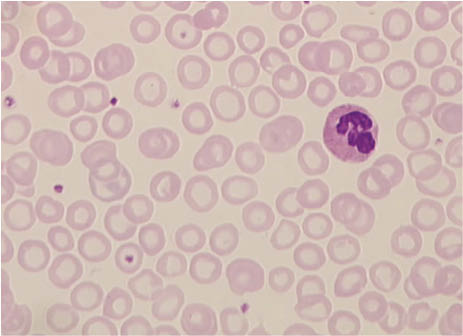
Figure 2: Peripheral blood film of a patient with an iron deficiency anemia.The erythrocytes are smaller than normal red blood cells. As a result of the lack of hemoglobin, there is an increase in central pallor, which occupies more than the normal approximate one-third of the red cell diameter. Most erythrocytes appear ring-shaped, known as anulocytes.
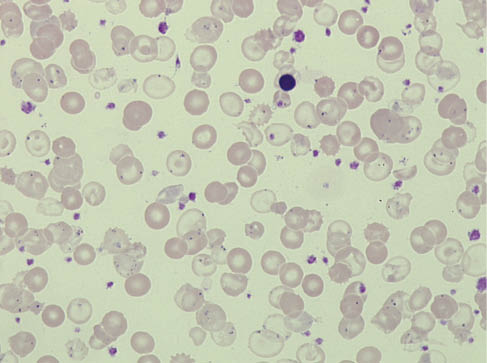
Figure 4: Smear of peripheral blood in the case of a transfusion-dependent β-thalassemia major.One sees an abundance of hypochromic anulocytes whose cell membrane is only slightly covered with hemoglobin, as well as individual target cells. Howell-Jolly bodies are present in some erythrocytes due to a splenectomy in the past, as are numerous Pappenheimer bodies (siderocytes), which indicate derangement of iron metabolism. Between the patient’s own erythrocytes, one can see transfused donor erythrocytes, one erythroblast and numerous platelets. Laboratory, see Table 4, patient 14.

Abstract
Anemia is defined as a decrease in the hemoglobin concentration below the age- and sex-specific lower limit, established by WHO as 130 g/L in men and 120 g/L in women. In principle, there are many differential diagnoses which must be considered. The diagnostic evaluation furthermore is complicated by the fact that anemias are often multicausal. A rational evaluation of anemia should always take into account the epidemiological data and also the individual patient’s history. The classification according to the size and the hemoglobin content of the red blood cells based on the erythrocyte indices still plays a central diagnostic role. The worldwide most important cause of a hypochromic-microcytic anemia is iron deficiency. Anemia of chronic disease (ACD) and thalassemia are to be considered as differential diagnoses. Disorders of vitamin B12 and folic acid metabolism are clinically the most important causes of hyperchromic-macrocytic anemia. The normochromic-normocytic group includes most forms of anemias. In these cases one should not try to cover all possible causes by a fully comprehensive laboratory panel within the first blood sample already. It is more appropriate to proceed step-by-step to evaluate the most frequent and clinically most important reasons first. This especially applies to geriatric and multimorbid patients where the diagnostic effort must be adjusted to the individual needs and prognosis of the patient, not only from economical but also from ethical reasons. In unexplained anemias, consultation of a hematologist should be considered. In case of doubt, bone marrow biopsy is required to precisely evaluate the hematopoiesis and to exclude a hematological disorder.
Reviewed Publication:
Nebe C.T.
Introduction
Anemia is defined as a decrease in hemoglobin concentration (Hb) below the age- and sex-specific reference values. Larger laboratories usually establish their own normative data based on regional measurements. Epidemiological studies mostly rely on the criteria set by a WHO expert group in 1968 [1]. According to this, the hemoglobin concentration depends on both age and sex with lower hemoglobin limits of 120 g/L for women and 130 g/L for men (Table 1).
Lower hemoglobin limit depending on age and sex according to the WHO [1].
| Hb lower limit, g/L | |
|---|---|
| Children 6 months to 6 years | 110.0 |
| Children 6–14 years | 120.0 |
| Men | 130.0 |
| Women, not pregnant | 120.0 |
| Women, pregnant | 110.0 |
A low hemoglobin concentration can have negative effects on the cardiovascular system, cognitive functions and quality of life. However, rather than being a disease itself, anemia should be considered the result of an underlying congenital or acquired disease or disorder. Therefore, the clinical picture of anemia is coupled with a wide array of differential diagnoses which the clinician should consider carefully. Given the high prevalence of anemia [2, 3], the diagnosis should be based on sound reasoning in order to minimize laboratory investigations and costs. Although it is obviously desirable to have a diagnostic approach tailored for an individual patient, it may be best to follow a standardized protocol and modify that as required by individual circumstances.
Epidemiology
In clinical practice, this standard protocol starts with a patient-based evaluation of the epidemiological data that one keeps at the back of one’s mind. You will encounter frequently that which is frequent but only rarely that which is rare (“if it’s rare it’s not on my chair”). This applies not only to general practitioners, but also to hospitals and – except for specialist outpatient clinics – university hospitals.
In children and adolescents, iron deficiency anemia and thalassemia are by far the most common forms of anemia in Europe – at least an order of magnitude more common than any other form [1, 4, 5].
In adults, anemia is mostly caused by an impaired iron supply for erythropoiesis. Premenopausal women and pregnant women are primarily affected by genuine, absolute iron deficiency. In those aged 65 and older, anemia of chronic disease (ACD), pathophysiologically due to disturbed iron metabolism, is the most common type of anemia accounting for approximately 20% of cases. Other frequent causes of anemia in geriatric patients include malnutrition and chronic renal insufficiency [2, 6–11].
Case history
Considering the patient’s history is an essential part of diagnosing anemia. The cause of anemia can be identified more effectively and more cost-efficiently if one knows about the patient’s social background, eating habits, as well as family and medical history. In this context, the clinical assessment of the anemia symptoms is also important. In other words: is there also a clinical manifestation of the decreased hemoglobin level or could it be merely related to the applied reference value. Older men are a good example. The physiological drop in testosterone level results in a decrease in hemoglobin, a fact that is not considered in the WHO reference ranges. Thus, a hemoglobin level of 120 g/dL obtained in an asymptomatic 80-year-old man is usually no reason to initiate an extensive diagnostic work-up.
Laboratory diagnostics
The first steps in the evaluation of anemia depend on the laboratory screening panel initially used. Typically, this includes the complete blood count, consisting of hemoglobin, red blood cell count, hematocrit, the erythrocyte indices mean corpuscular volume (MCV) and mean corpuscular hemoglobin (MCH), the number of platelets and leukocytes, as well as the differential blood count. Reticulocytes usually have to be ordered separately and are not typically available at the initial evaluation.
First, one should look at the differential blood count. When blasts are detected, it is indicative of a serious, underlying hematological disease that requires immediate admission, or referral to a hematologist. Also with a white blood cell count of over 25×109/L and in the absence of other obvious causes, the patient should be referred to a specialist in order to exclude a hematologic neoplasm. Although platelet counts above 500×109/L can also occur reactively, for example, in the context of iron deficiency, a myeloproliferative neoplasm should be assumed unless proven otherwise.
In the case of an isolated anemia, the further diagnostic measures depend on the size and hemoglobin content of the erythrocytes. If the reticulocyte count is already available at this point, the anemia can be divided into a hyper-regenerative (reticulocytes >100/μL) and a hypo-regenerative form. This distinction is valuable because a hyper-regenerative anemia really only occurs, with the exception of therapy-related regenerations, in a subacute hemorrhage or hemolytic anemia. Both cases require immediate action in the form of further diagnostics or intensive medical care.
If the reticulocytes are not elevated, or they are not yet available, an initial diagnosis has to be based on the red cell indices, MCV and MCH. The classification is then made in favor of hypochromic-microcytic (MCH <27 pg, MCV <80 fL), normochromic-normocytic (MCH 27–34 pg; MCV 80–96 fL) or hyperchromic-macrocytic (MCH >34 pg; MCV >96 fL). This “time-honored” classification is still valid from the clinical perspective because it ensures that the most important types of anemia, and in particular those with the most severe consequences, are not being missed (Figure 1). A hypochromic-microcytic anemia is to be considered the result of an iron deficiency, and to be investigated as such, until proven otherwise. In the case of a hyperchromic-macrocytic blood count, one initially assumes a vitamin B12/folic acid deficiency and acts accordingly in order to prevent permanent damage to the patient.

Classification of anemia according to the red cell indices.
Hypochromic-microcytic anemia
In theory, there are several possible causes of hypochromic-microcytic anemia (Figure 1). But only three of them matter in clinical practice: iron deficiency anemia, ACD and thalassemia. What are the typical characteristics of these forms of anemia and how can one tell them apart most easily?
Iron deficiency anemia
A negative iron balance first causes a storage iron depletion (stage I), where the total body iron is decreased, without the synthesis of hemoglobin being affected. In this stage, there is no immediate clinical dysfunction. In stage II, the iron-deficient erythropoiesis, iron deficiency becomes a disease, as the amount of iron is no longer sufficient to meet the requirement of the erythropoietic precursors in bone marrow. The hemoglobin concentration, however, is still within the reference range. Finally, when the iron supply is insufficient to maintain a normal hemoglobin concentration, stage III of iron deficiency, the iron deficiency anemia (Figure 2), is reached.
Peripheral blood film of a patient with an iron deficiency anemia.
The erythrocytes are smaller than normal red blood cells. As a result of the lack of hemoglobin, there is an increase in central pallor, which occupies more than the normal approximate one-third of the red cell diameter. Most erythrocytes appear ring-shaped, known as anulocytes.
There are several iron parameters that can be used to assess the iron metabolism of a person. It is, however, important always to bear in mind that these tests indicate something different in terms of iron deficiency [12]. The individual parameters do not measure a single entity called “iron deficiency” but they are related to a specific stage of iron deficiency (Figure 3). Ferritin reflects the amount of iron stored, but says nothing about the iron supply for the red cell precursors in bone marrow. This requires other parameters which allow to monitor the supply of the erythropoiesis with iron. These include zinc protoporphyrin (ZPP), the soluble transferrin receptors (sTfR), the hypochromic erythrocytes (HYPO) and reticulocyte hemoglobin (CHr). An indirect indication of iron-deficient erythropoiesis is provided by a reduced transferrin saturation of ≤15%. Finally, a hemoglobin analysis is required to confirm the drop in hemoglobin below the lower limit and, thus, to diagnose the most severe form of iron deficiency, the iron deficiency anemia [13]. Consequently, there is no such thing as the “best iron parameter”. In detecting different stages, the various tests, however, efficiently complement one another in order to characterize the severity of the iron deficiency in the individual patient.

Laboratory parameters of iron metabolism and their sensitivity.
According to WHO recommendation, the best way to determine the iron status of an individual is to analyze the serum ferritin level [14]. From the theoretical point of view, this is correct, because ferritin is the only laboratory parameter that reflects the iron stores and, thus, captures iron deficiency at the earliest stage. A serum ferritin <12 μg/L is deemed proof of storage iron deficiency. However, even levels <22 μg/L seem to be associated with a clinically relevant storage iron depletion [15].
There is, however, a potential problem when using ferritin as a screening parameter of iron deficiency, because ferritin is also an acute-phase protein that co-reacts in connection with inflammatory disorders, as well as in liver diseases. Therefore, ferritin measurement is only of limited use in particular in multimorbid patients. Caution should be exercised in this regard also in the case of the elderly: Aging goes hand-in-hand with a subclinical inflammatory process that can elevate the serum ferritin concentration and, thus, mask an existing iron deficiency [16].
The general recommendation in connection with a normal or elevated ferritin level is that an additional acute-phase protein should be examined in order to rule out a false-normal ferritin concentration [17]. As a rule, the C-reactive protein (CRP) is used for this purpose. But this does not quite solve the problem yet, since ferritin exhibits a different dynamics than CRP in the inflammatory process, which causes that about 15% of cases of iron deficiency are not detected even when this tandem analysis is employed. Meanwhile, recommendations have been issued that suggest that the α1-acid glycoprotein should be used as a further acute-phase protein in addition to CRP. But this does not make the diagnostics any cheaper [18].
Given the diagnostic uncertainty of ferritin, there is a clear need for a diagnostic alternative, particularly in multimorbid patients. This alternative is provided by the parameters of iron-deficient erythropoiesis that monitor the iron supply for erythroid precursors. ZPP is of particular diagnostic value. It is produced instead of heme when the iron support to the erythropoiesis becomes insufficient and zinc, instead of iron, is incorporated into protoporphyrin IX. The measurement therefore captures all disturbances of the iron metabolism, not only the absolute iron deficiency [19, 20]. False-elevated levels, by contrast, are measured only in the very rare congenital, erythropoietic porphyria. The ZPP analysis prompts the clinician to the following question: “Does the anemia have anything to do with iron?” The clear answer: yes, or no. Values within the normal range rule out disorders of the iron metabolism except for an isolated depletion of the iron stores (stage I). Elevated levels provide proof of iron-deficient erythropoiesis, and also allow for an assessment of their clinical significance. Typically, you would consider an anemia when the ZPP reaches twice the standard value, ie ZPP >80 μmol/mol heme. In the case of severe forms of anemia with a hemoglobin level <90 g/L, ZPP is usually >200 μmol/mol heme, and a long-lasting iron-deficient erythropoiesis can produce concentrations of up to 1000 μmol/mol heme.
To proof the existence of an iron deficiency beyond doubt requires the analysis of one of the parameters of the iron-deficient erythropoiesis in addition to ferritin (Table 2). Here, HYPO, CHr and sTfR have a key advantage over ZPP, because their analysis was automated. However, they do not solely depend on the iron metabolism, which means that other factors, too, must be considered when interpreting them. For HYPO and CHr, these are generally all factors that affect the erythrocytic hemoglobin concentration, but also, above all, those that cause a hyperchromic blood count. In the case of sTfR, it is especially the quality and quantity of erythropoiesis that is reflected in the measured serum levels, apart from the iron metabolism [21]. Chronic lymphocytic leukemia, too, causes an increase in the sTfR concentration in correlation with the tumor burden, even though there is no iron deficiency present [22].
Typical constellation of iron parameters at different stages of iron deficiency.
| Stage | I | II | III |
|---|---|---|---|
| Storage iron depletion | Iron-deficient erythropoiesis | Iron-deficiency anemia | |
| Ferritin | ↓ | ↓ | ↓ |
| Transferrin saturation | n | ↓ | ↓ |
| CHr | n | ↓ | ↓ |
| HYPO | n | ↑ | ↑ |
| ZPP | n | ↑ | ↑ |
| sTfR | n | ↑ | ↑ |
| Hemoglobin | n | n | ↓ |
Depending on the desired sensitivity and specificity, different cut-off values were proposed for HYPO and CHr in the past. Now, the preferred proof of iron-deficient erythropoiesis is usually HYPO >5% and CHr <28 pg [23]. The situation is somewhat more complex for sTfR. The parameter is measured using different methods that use calibrators with varying degrees of transferrin affinity. This results in test-dependent reference values, some of which differ from each other quite considerably (e.g. 0.4–1.8 mg/L for Dade Behring and 0.7–4.2 mg/L for Nichols Institute). In addition, reference values were not always obtained from individuals whose iron metabolism had been studied carefully. Consequently, the “normal population” also included people with an iron deficiency. This can be seen when considering the different reference values for males and females, even though people without an iron deficiency do not exhibit any sex-specific differences in their sTfR concentration. Furthermore, the manufacturer’s reference values were partially revised on the basis of investigations done on a group of individuals whose iron status was defined precisely [15, 24]. In order to fully exploit the potential of this diagnostically superior parameter, it is therefore recommended to check the quality of the stated reference values against the literature, or even to derive one’s own reference values for the sTfR test used.
Anemia of chronic disease
Anemia of chronic disease (ACD) is also caused by an iron-deficient erythropoiesis. In contrast to the genuine, absolute iron deficiency, the iron deficiency in the context of ACD is only of a functional nature. The pathogenesis of ACD is complex and multifactorial. The focus is on hepcidin-triggered iron deprivation, which puts the body in a state of functional deficiency. Although iron is abundantly available in the body, to provide an unspecific defense mechanism, it is blocked within the reticulo-endothelial system. As a result, iron is unavailable to the pathogen or the inflammatory process – but unfortunately also to the erythropoiesis [25–27].
Any inflammatory or malignant process can induce ACD, but only if it persists for, typically, at least six to eight weeks. Particularly noteworthy here are autoimmune diseases (e.g. polymyalgia rheumatica, rheumatoid arthritis, systemic lupus erythematosus), chronic infections (e.g. tuberculosis, osteomyelitis, endocarditis) and malignancies. A substantial amount of the anemia of the elderly is also ACD, caused by cytokine imbalance. Acute inflammation also causes an iron blockade, but this is without clinical significance due to the short duration of the disease and the long life span of the erythrocytes.
ACD plays an important role in clinical practice. It is, in fact, regarded as the most common type of anemia in hospitalized patients and the elderly [6, 7, 10]. However, it must be emphasized that not every anemia occurring in a chronic disease is ACD; it is only those that can be linked pathophysiologically to a cytokine-induced derangement of iron metabolism. Therefore, the epidemiological surveys on ACD should be treated with caution, since the diagnosis in such cases is usually based only on a ferritin and/or CRP analysis.
ACD can only be proven beyond doubt by examination of a Prussian blue stain of a bone marrow smear. This can confirm both the sufficient amount of iron in reticulo-endothelial stores and the iron-deficient erythropoiesis, which becomes obvious by decrease of the iron-containing red cell precursors. A bone marrow biopsy is of course not always possible, nor is it necessary in most cases to arrive at a reliable ACD diagnosis.
The key task of ACD diagnostics consists in confirming iron-deficient erythropoiesis and ruling out an absolute iron deficiency. This can be done very easily with two parameters, ZPP and sTfR. ZPP captures all derangements of iron metabolism, including those related to ACD [28]. The sTfR concentration, on the other hand, is elevated only in the case of a genuine, absolute iron deficiency; with ACD, it remains within the reference range [29, 30]. Valuable information is also obtained from the ZPP level: levels >150 μmol/mol heme are observed only in connection with a very severe form of ACD. ZPP >200 μmol/mol heme virtually never occurs with ACD, and suggests an iron deficiency anemia. In other words, the insufficient iron supply for erythropoiesis in the case of ACD is not as pronounced as in an anemia that is caused by absolute iron deficiency. Accordingly, the ACD in most cases is normochromic-normocytic. A hypochromic-microcytic blood count develops only after a long and severe course of the chronic illness. However, MCV levels <70 fL are practically never reached.
Of course, one can ignore ZPP and sTfR and work only with the traditional parameters, but the diagnostics would then be more difficult and not entirely clear, particularly if the erythrocytes are only borderline microcytic. Decreased transferrin saturation in such cases points to an iron-deficient erythropoiesis. CHr <28 pg confirms a current insufficient supply for erythropoiesis, while an increase in HYPO >5% indicates that the insufficient supply has already persisted for some time. But none of this makes any difference between iron deficiency anemia and ACD. By this point, at the latest, one must analyze the sTfR, or rely on elevated ferritin. CRP does not really help much in this situation. Although elevated CRP is traditionally part of ACD, it also renders the assessment of elevated ferritin more difficult, by signaling that the ferritin might also be false-normal. In other words, iron deficiency anemia would produce precisely the same laboratory constellation in connection with an acute inflammation. To be honest, one must admit that in clinical practice, and when an underlying chronic disease is known, ACD diagnoses have been only assumptions more often than they have been confirmed beyond doubt. It would help diagnostically to know the serum level of hepcidin, which is reduced with iron deficiency anemia and elevated with ACD [31, 32]. Several laboratories now offer this parameter and we would expect that it will play a key role in the differential diagnosis in the future. It has not been standardized yet, which means that the measured values depend on the method (ELISA, mass spectrometry) and standard used and on the respective ability to capture the isoforms hepcidin-20 and hepcidin-22 in addition to the bioactive hepcidin-25 [33].
Patients with ACD and a co-existing iron deficiency, not uncommon in rheumatoid arthritis, present a particularly challenging constellation. Diagnosis with conventional iron parameters was notoriously problematic and could generally only be made by bone marrow biopsy. In those cases, too, sTfR proved extremely helpful after it had been shown that it is able to detect absolute iron deficiency even in combination with a chronic inflammation. As long as sTfR is within the reference range, one assumes a “simple” ACD in patients with chronic inflammatory diseases. If, however, the sTfR concentration is elevated the diagnosis changes in favor of an ACD with a co-existing iron deficiency [15, 24]. This challenging differential diagnosis underlines the demand for a clear cut-off value to be applied to sTfR in order to differentiate between patients with and without iron deficiency.
To improve the diagnostic reliability of sTfR for confirming or ruling out iron deficiency in complex cases of anemia, the TfR-F index was introduced [15, 24]. This parameter represents a ratio of the serum sTfR value and the common logarithm of serum ferritin concentration. It can be used to distinguish between patients with iron deficiency and those without: patients with iron deficiency exceed a cut-off value. Our preference is in favor of separate interpretation of the individual parameters sTfR and ferritin. This is based on the following reasons. First, the index reduces two meaningful parameters to a single, imaginary value. Second, in our study we have not been able to show the superiority of the TfR-F index [22]. Finally, the cut-off values of the TfR-F index are test-dependent (see above) and in some cases differ substantially from each other (R&D Systems: >1.5; Dade Behring: >1.5; Orion Diagnostica: >2.2; Nichols Institute: >3.5; Roche Diagnostics: >3.8), which does not facilitate the diagnosis. When the interpretation of the sTfR results becomes problematic as in conditions with increased erythropoiesis or in chronic lymphocytic leukemia, the sTfR-F index does not provide any diagnostic help when compared to the sole sTfR analysis [34].
To estimate the proportion of the erythropoiesis on the concentration of sTfR, and to consider it in the differential diagnosis, the “Thomas plot” combines the TfR-F index with CHr as a second parameter of iron-deficient erythropoiesis that is independent of the erythropoietic activity [23]. Even though the above objections to the TfR-F index apply here as well, and the cut-off value of TfR-F is not only test-dependent, but also shifts relative to CRP, the four-quadrant plot provides a rough guide for classifying anemias: anemias can be assigned to one of the four quadrants depending on their cause. Quadrant 1 (TfR-F index <cut-off, CHr >28 pg) contains anemias with a normal hemoglobin content, with normal or reduced erythropoiesis (e.g. ACD, renal anemia, hypo-regenerative anemias, myelosuppression), while Quadrant 2 (TfR-F index >cut-off, CHr >28 pg) contains hyper-regenerative anemias and iron deficiency anemias undergoing substitution therapy and/or cases with slight iron-deficient erythropoiesis. Typical iron deficiency anemias are located in Quadrant 3 (TfR-F index >cut-off, CHr <28 pg) and anemias involving derangements of iron metabolism and disorders causing a reduced hemoglobin production (e.g. severe ACD, ACD combined with iron deficiency, thalassemia), in Quadrant 4 (TfR-F index <cut-off, CHr <28 pg).
Thalassemia
In the case of thalassemia, the hypochromic-microcytic blood count is due to a deficit in hemoglobin production, resulting from a genetically caused, reduced or absent function of one or more globin genes. Since hemoglobin, from the seventh month of life, physiologically consists of 95%–98% HbA1, composed of two α and two β chains, only the α and β thalassemias are important in clinical practice. The clinical picture and also the laboratory parameters may vary greatly depending on the respective genetic mutation and the number of affected genes.
β-Thalassemia major (Figure 4) generally does not cause diagnostic problems. It is characterized by a severe, transfusion-dependent hypochromic-microcytic anemia (mostly since early infancy) that is caused by a severe reduction or total lack of synthesis of the β globin chains.
Smear of peripheral blood in the case of a transfusion-dependent β-thalassemia major.
One sees an abundance of hypochromic anulocytes whose cell membrane is only slightly covered with hemoglobin, as well as individual target cells. Howell-Jolly bodies are present in some erythrocytes due to a splenectomy in the past, as are numerous Pappenheimer bodies (siderocytes), which indicate derangement of iron metabolism. Between the patient’s own erythrocytes, one can see transfused donor erythrocytes, one erythroblast and numerous platelets. Laboratory, see Table 4, patient 14.
More difficult is the recognition of a β-thalassemia minor, in which case the production of the β chains is only slightly reduced, so that often no or only mild anemia occurs. Nevertheless, it results in a hypochromic-microcytic blood count that does not match the marginally normal hemoglobin, therefore allowing the differential diagnosis from an iron deficiency anemia. Another difference from iron deficiency anemia is the mostly normal MCHC (normal: 32–36 g/dL) and minimal anisocytosis (red cell distribution width, RDW <15%). The disease is confirmed by hemoglobin electrophoresis or HPLC by detecting elevated HbA2 (normal: <3.2%). However, it should be noted that the production of HbA2 is selectively reduced in connection with iron deficiency, so that iron deficiency can mask a β-thalassemia minor. In this context, ZPP is helpful because it can exclude a significant iron-deficient erythropoiesis and substantiate the HbA2 finding. However, the ZPP analysis is generally useful in cases of suspected thalassemia. In contrast to iron deficiency anemia, it is normal or only slightly elevated in thalassemia minor, and thus already resolves the differential diagnosis. Elevated ZPP value measured in a case of thalassemia minor points to additional iron deficiency. Ferritin does not help with the differential diagnosis. It does check the iron stores, but does not allow for any conclusions about the iron supply for erythropoiesis. In cases of β-thalassemia intermedia, ZPP of up to 100 μmol/mol heme can be observed. This increase is due to the significantly elevated, ineffective erythropoiesis when the system capacity for an optimal iron support is exceeded. Similar observations are made with other highly hyper-regenerative anemias.
In α-thalassemia, the situation is somewhat more complicated. The existence of the α chain (being the most important globin chain) is secured by four α genes. The failure of all four genes is incompatible with survival and ends in hydrops fetalis. The absence of three genes results in a chronic hemolytic anemia with hemoglobin levels of 60–100 g/L, as well as in a significant reduction in MCV, MCH and MCHC and a pronounced anisocytosis with elevated RDW. The diagnosis is confirmed by means of hemoglobin electrophoresis or HPLC with detection of hemoglobin H (HbH) consisting of four β chains. If so suspected, HbH-containing erythrocytes can be easily detected by their classic golf ball morphology using brilliant cresyl blue supravital staining. This requires, however, a staining incubation time of 3–4 h.
While the severe forms of α thalassemia can hardly be overlooked, the loss of one or two α genes, a condition known as α-thalassemia trait, poses a real diagnostic challenge. The patients are clinically asymptomatic and have normal hemoglobin levels. However, the red cell indices are usually lowered, which is often misinterpreted as iron deficiency. Thus, one should always suspect an α-thalassemia trait when a person of an appropriate ethnic group has a hypochromic-microcytic blood count, is not iron deficient and has a normal hemoglobin electrophoresis and normal HbA2 – at least until proven otherwise. Real proof of the α-thalassemia trait can only be obtained by DNA analysis. Hemoglobin electrophoresis and HPLC yield normal readings, except during the neonatal period when a low amount of hemoglobin Bart’s (γ4) and HbH may be detected.
Practical consequences
What are the consequences for clinical practice? An “all-inclusive panel” that allows for an adequate clarification of the main causes of hypochromic-microcytic anemia, in our view, would contain the following parameters: reticulocytes, ferritin, transferrin saturation, ZPP, sTfR, CRP, ALAT, hepcidin and hemoglobin electrophoresis. It is obviously of benefit to adapt or condense this panel for each patient. For example, in young women with hypochromic-microcytic anemia, a ferritin analysis is usually diagnostically sufficient. Hemoglobin electrophoresis is generally carried out only when there is a real suspicion of a hemoglobin abnormality, or in case of an unexplained anemia.
When determining an iron supply deficiency for the erythropoiesis, preference is frequently given to HYPO and CHr over ZPP, because ZPP analysis cannot yet be automated. Regardless, we prefer ZPP because it is the only parameter that detects directly, selectively and quantitatively an iron-deficient erythropoiesis and not only its consequences.
Hyperchromic-macrocytic anemia
The group of hyperchromic-macrocytic anemias comprises mainly the types of anemia that are caused by an impairment of cell division – primarily by an impairment of DNA synthesis. The most important clinical causes are vitamin B12 and folic acid deficiency [35–39].
Pathophysiological similar are anemias that are associated with medications that affect the folic acid metabolism as well as all those that impair DNA synthesis such as cytostatics or immunosuppressants. When it comes to minimal macrocytosis with only marginally increased MCV, one must also consider alcohol-induced anemia and, particularly, hyper-regenerative hemolytic anemia, because the reticulocytes are substantially larger than normal erythrocytes, which shifts the MCV up. Myelodysplastic syndromes (MDS) constitute an important differential diagnosis in geriatric patients. Macrocytic anemia, caused by impaired DNA synthesis and cell division, is also often observed in these cases. MDS is, however, rare in people younger than 50.
Vitamin B12 and folic acid
The clinically most important anemia in this group is caused by an impaired folic acid/B12 metabolism. Based on the characteristic bone marrow appearance with a predominance of conspicuous red cell precursors, known as megaloblasts, it has been given the generic name megaloblastic anemia. The DNA synthesis derangement in these cases is due to an impairment of thymidylate synthase, accompanied by a reduced conversion of deoxyuridine monophosphate to deoxythymidine monophosphate. This reaction requires folic acid, which in turn needs vitamin B12. Vitamin B12 demethylates the folic acid and, thus, renders it functional. The separated methyl group is transferred to homocysteine, which is converted to methionine as a result. A serum analysis for homocysteine, therefore, offers a simple way of checking this, highly complex, metabolic pathway. Serum homocysteine is elevated (Figure 5) if there is a lack or any other impairment of vitamin B12 and/or folic acid. However, with only borderline elevated levels, one must keep in mind that the increase in homocysteine can also have other causes, primarily renal failure, alcohol abuse and, in particular, technical problems in processing the blood sample [40]. The diagnostically more reliable alternative in checking the entire vitamin B12 metabolism is believed to be the measurement of the plasma concentration of methylmalonic acid (MMA) – the MMA analysis is more sensitive and more specific than that of homocysteine. But it is also significantly more expensive and not available everywhere. It is therefore used in clinical practice only in diagnostically problematic cases. As is true of homocysteine, the MMA concentration, too, can be false-elevated in renal insufficiency [40].

About 80% of vitamin B12 in peripheral blood is bound to a glycoprotein from the group of transcobalamins, haptocorrin (formerly transcobalamin I).
This complex is referred to as holo-haptocorrin (Holo-HC) and is biologically inactive. Its task presumably consists of returning excess vitamin B12 to the liver. The supply for the cells is the sole responsibility of holo-transcobalamin II (Holo-TC), which carries only around 20% of vitamin B12 in peripheral blood. Holo-TC binds to a specific transcobalamin II receptor (TCR). This is then absorbed into the cell as part of a vesicle. After this bond is broken down, the TCR is recycled, the transcobalamin II is broken down lysosomally, and vitamin B12 is supplied to the cell. The vitamin-B12-dependent reactions are impaired in the case of an intracellular lack of functional vitamin B12. From the diagnostic point of view, the impaired breakdown of homocysteine and methylmalonyl-CoA is significant, because one can analyze these parameters in peripheral blood to check the functionality of the entire vitamin B12 metabolism.
The preferred clinical practice is the serum analysis of the individual parameters vitamin B12 and folic acid, rather than doing a global check of the entire system. A cut-off of 200 ng/L has traditionally been applied to vitamin B12, upon several studies had shown that 60%–80% of people with a level <200 ng/L suffer from a clinically significant vitamin B12 deficiency [40]. However, higher levels do not rule out a clinically relevant vitamin B12 deficiency. This has to do with the fact that around 80% of the vitamin circulating in the blood is bound to haptocorrin, in a biologically inactive complex. Only a small fraction that is bound to transcobalamin II, known as holo-transcobalamin (Holo-TC), is biologically active and capable of supplying cells with vitamin B12. Holo-TC tests are now commercially available, and are offered and recommended particularly at the early stage of vitamin B12 deficiency. This test also makes sense in the context of an unexplained hyperchromic-macrocytic anemia in order to check the vitamin B12 supply for erythropoiesis. The reference range for Holo-TC is 40–200 pmol/L. Lower values indicate a deficiency of bioactive vitamin B12 [41].
In the case of folic acid, one must note that the serum folic acid concentration only reflects the situation of the last one to two weeks and that it does not rule out anemia caused by folic acid deficiency. To do so, one must examine the erythrocytic folic acid, which allows for an assessment of the last 2–3 months, according to the lifespan of the red cells. Considering that the folic acid in the erythrocytes represents 95% of the total folic acid in the blood, it is clear that even a minimal hemolysis can distort the folic acid concentration significantly.
The morphological findings of the vitamin B12/folic acid deficiency in the bone marrow, with markedly elevated, left-shifted, ineffective erythropoiesis, are reflected in the hemolysis parameters. LDH is considerably elevated and is mostly around 1000 U/L; bilirubin is slightly elevated, at around 2 mg/dL. Deficiency of vitamin B12 and folic acid does, however, not only affect erythropoiesis, but the entire hematopoiesis. Thus, the picture of a severe vitamin B12 and/or folic acid deficiency may also include leukopenia with hypersegmented neutrophils and thrombocytopenia with levels that can fall below 50×109/L.
Given the rather complex metabolism (Figure 6), a vitamin B12 deficiency can have a wide range of causes. First of all, one must rule out pernicious anemia, an autoimmune disease with type A gastritis and antibodies against the intrinsic factor and parietal cells. Gastric cancers are frequent with pernicious anemia, so that patients require regular gastroenterological monitoring. However, a vitamin B12 deficiency may also occur in other malabsorption disorders (atrophic gastritis, gastric resections, exocrine pancreatic insufficiency, bowel resections, vitamin-B12-consuming intestinal bacteria, fish tapeworm, Crohn’s disease, coeliac disease, Zollinger-Ellison syndrome, calcium deficiency). Other causes include inadequate intake (vegans, alcoholics, goat’s milk), increased demand (pregnancy, hemolysis, neoplasias, hyperthyroidism), medications (colchicine, neomycin, metformin), inactivation by nitrous oxide, or congenital problems (intrinsic factor abnormalities, transcobalamin deficiency, Imerslund-Gräsbeck syndrome).

Scheme of the vitamin B12 metabolism.
The dietary supply of vitamin B12 is through animal source foods, broken down in the stomach (if digestion works properly) and bound to haptocorrin. In the duodenum, this compound is cleaved by pancreatic enzymes and vitamin B12 is transferred to the intrinsic factor, under the protection of which it reaches the terminal ileum. Here, at a pH >5.4 and in the presence of Ca2+, it binds to intrinsic factor receptors and is absorbed. The absorbed vitamin B12 is first taken up by transcobalamin II. Most of the vitamin, however, is transferred in the liver to haptocorrin and secreted via the bile into the duodenum, creating an enterohepatic circulation. Thanks to the enterohepatic circulation, the human organism is able to compensate a complete lack of vitamin B12 intake for 3–6 years, although the physiological body stores of vitamin B12 are only 2–5 mg.
Apart from an insufficient supply, folic acid deficiency can be caused particularly by an increased demand (pregnancy, hemolysis, neoplasias, stress). Other causes include drugs (barbiturates, anticonvulsants, contraceptives, sulfasalazine) and in particular folic acid antagonists used for therapeutic purposes (methotrexate, pemetrexed, sulfonamides, trimethoprim, pyrimethamine, triamterene). Congenital causes (dihydrofolate reductase deficiency, formiminotransferase deficiency), however, are rare.
Myelodysplastic syndromes
Myelodysplastic syndromes (MDS) represent a heterogeneous group of diseases that are predominantly diagnosed in the elderly [42]. The peak incidence is between 70 and 80 years of age; before 50 years of age, MDS is rare. The common feature of MDS is an ineffective hematopoiesis, which affects one or more cell lines. The bone marrow is usually normocellular, or even hypercellular, while cytopenias are found in peripheral blood. The clinical picture depends on the affected cell line and on the degree of cytopenia. The full picture of MDS is characterized by a pronounced pancytopenia with transfusion-dependency, susceptibility to infection and bleeding. In 20%–30% of cases, a transformation to acute myeloid leukemia occurs.
Most MDS patients present with a more or less severe anemia, which is typically normochromic and normocytic or macrocytic. The number of reticulocytes may be normal or reduced. This also applies to sTfR, where serum concentration is typically normal, or even decreased, in spite of the increased erythropoiesis due to the poor maturation of the red cells. A particular MDS entity is the so-called 5q– syndrome, which is cytogenetically characterized by a deletion of the short arm on chromosome 5. The disease affects mainly older women and is characterized by a mostly isolated, macrocytic anemia.
Practical consequences
In the presence of hyperchromic-macrocytic anemia, vitamin B12 and folic acid deficiency must initially be excluded. The laboratory panel used should include at least reticulocytes, LDH, bilirubin, vitamin B12 serum level and erythrocytic folic acid. To also identify more complex disorders, we recommend serum homocysteine to be added to the battery of laboratory tests. In the case of a vitamin B12 deficiency, it is necessary to confirm or rule out a pernicious anemia (gastroscopy, antibodies). If the cause of a macrocytic anemia remains unclear and also not be explained on the basis of a patient’s history regarding eating habits, comorbidities and medication, the patient should be referred to a hematologist in light of the required substantial diagnostic effort.
Macrocytic anemia in people aged 50 or older warrants special attention. If the blood count in this patients group can neither be explained by a vitamin B12 and/or folic acid deficiency, nor normalized by way of substitution, one should first (and foremost) assume MDS. Here, too, the patient should be referred to a hematologist, because even a suspected diagnosis already warrants a timely bone marrow biopsy, including cytology, histology, flow cytometry, cytogenetics and molecular testing.
Normochromic-normocytic anemia
In contrast to hypochromic-microcytic and hyperchromic-macrocytic anemias, which are usually relatively easy to clarify, normochromic-normocytic anemias frequently pose a real diagnostic challenge to the clinician. On the one hand, this has to do with the fact that this group comprises most types of anemia. On the other hand, anemias often have more than one cause. In fact, they are multfactorial in about 30% of cases [9]. If several components co-exist, they can mask classical types of anemia, so that also iron deficiency, or vitamin B12 and/or folic acid deficiency can give rise to a normochromic-normocytic anemia.
There is one diagnostically important question that should be answered right at the start of doing a work-up on this anemia group: Is the anemia hyper- or hypo-regenerative? Traditionally, this question is answered by the measurement of the reticulocytes. Hyper-regenerative anemias are characterized by a reticulocyte count >100/μL, the counts are lower in hypo-regenerative types. A hyper-regenerative anemia may be caused by an elevated erythropoiesis during or following therapy (chemotherapy, erythropoietin substitution, vitamin B12 or iron substitution), but also by a subacute hemorrhage or hemolysis. A subacute hemorrhage requires immediate referral and consideration by internal and particularly gastroenterological specialists.
The suspected diagnosis of hemolysis is substantiated by an increase in LDH and indirect bilirubin, as well as by a reduction in haptoglobin. In the presence of hemolysis, one should first look at the patient’s history and find out whether a congenital disorder of the red blood cells (disorder of hemoglobin synthesis, enzyme defect, defective membrane) could be the underlying cause (Figure 7). The assessment of the peripheral blood smear is then followed by hemoglobin electrophoresis in these cases, as well as by measurement of the erythrocyte enzymes (G6PDH, pyruvate kinase), analysis of osmotic fragility and the EMA test (spherocytosis). Given the costs of these specialized tests, they are usually ordered by a hematologist.

Work-up of hemolytic anemia.
If congenital anemia is unlikely, the next step should be about ruling out fragmentocytes and, thus, a microangiopathic anemia in connection with thrombotic thrombocytopenic purpura (TTP) or a hemolytic uremic syndrome (HUS), because it constitutes a therapeutic emergency that must be treated immediately by plasmapheresis [43, 44]. This diagnosis should be considered first and foremost when the patient is young and has thrombocytopenia. If microangiopathic anemia is suspected, it is recommended to measure the activity of metalloprotease ADAMTS13 before starting the treatment [45].
Exclusion of microangiopathic anemia is followed by the Coombs test to verify an immunohemolysis [46]. In this context, one should keep in mind that five to ten percent of immunohemolytic anemias are Coombs test negative [47]. This can be the result of a range of causes. Generally, though, this is due to the fact that the autoantibodies in these cases are more effective than the Coombs serum used in the test, which reacts only once there is a load of 500 IgG molecules per erythrocyte. IgG3 and IgA autoantibodies, in particular, cause hemolysis at significantly lower loads. Even low-affinity IgG can trigger hemolysis by complement activation, which is not detected by a conventional Coombs test.
Before considering rare causes of hemolysis, such as mechanical hemolysis (march hemolysis, heart valve), hemolysis in connection with infectious diseases (malaria, gas gangrene) or due to toxic exposure (chemicals, drugs, animal poisons), one should first order a flow cytometry analysis (FACS) of peripheral blood to rule out a monoclonal lymphoid population and, thus, an underlying hematological neoplasia. The diagnosis of the only acquired corpuscular hemolytic anemia, the paroxysmal nocturnal hemoglobinuria (PNH), which is characterized by sudden-onset hemolysis with dark morning urine, as well as by thrombophilia, has meanwhile also become a domain of FACS. The low expression of the glycosylphosphatidylinositol (GPI)-anchored surface molecules CD55 and CD59 can be established not only on the erythrocytes, but also on neutrophils and on monocytes, which allows an unequivocal diagnosis even after a hemolytic episode, when the erythrocytic PNH clone has largely disappeared [48, 49].
After excluding a hyper-regenerative anemia, the entire range of hypo-regenerative types remains as differential diagnosis. The most common ones are combined anemias, recent ACD, myelosuppression and especially the renal anemia. In order to clarify these cases, the measurement of sTfR proved itself valuable, particularly when performed in tandem with its natural diagnostic partner, ZPP [50]. The sTfR concentration depends on the iron metabolism, as well as on the quantity and quality of the erythropoiesis. Elevated sTfR is measured not only in iron deficiency, but also when the erythropoiesis is increased. A tandem analysis of sTfR and ZPP thus provides valuable information, especially if the erythropoietin level is measured at the same time. This way, it is possible to confirm or rule out an iron-deficient erythropoiesis, while also diagnosing ACD, which typically starts as a normochromic-normocytic anemia before turning into the hypochrom-microcytic form as the disease progresses.
Normal ZPP values exclude any relevant problem of the iron metabolism. In these cases, the quantity and quality of erythropoiesis can be derived directly from the sTfR concentration (Table 3). A hyper-regenerative anemia in hemolysis is associated with elevated sTfR. Elevated levels are also observed with megaloblastic anemias, which are associated with an increased, relatively well maturing erythropoiesis. MDS, by contrast, exhibit normal or reduced sTfR concentrations, despite the elevated erythropoiesis, because the erythropoiesis matures poorly, and because the immature red cell precursors carry substantially fewer transferrin receptors than the more mature erythroblasts. Hypoplasia and aplasia of erythropoiesis can be recognized by a significantly decreased sTfR. This relates to therapeutically induced myelosuppression following chemotherapy, but also to the pure red cell aplasia (PRCA), which is characterized by virtually absent sTfR coupled with extremely high erythropoietin levels (Table 4).
Clarification of anemias based on ZPP and sTfR [50]. IDE, iron-deficient erythropoiesis; EP, erythropoiesis; ACD, anemia of chronic disease.
| ZPP | sTfR | Diagnosis |
|---|---|---|
| normal | normal | no IDE, EP normal |
| ↑ | ↑ | Iron deficiency |
| ↑ | normal | ACD |
| normal | ↑ | no IDE, EP elevated |
| normal | ↓ | no IDE, EP reduced |
Examples of individual patients with various types of anemia, including the relevant laboratory parameters. Key differential-diagnostic parameters are, in particular, zinc protoporphyrin (ZPP), the soluble transferrin receptors (sTfR) and serum erythropoietin (EPO), because they allow for an assessment of the iron metabolism and of erythropoietic activity in the bone marrow.
| No. | Diagnosis | Hb g/L | MCV 80–98 fL | Reti 25–102 ×109/L | CHr 28–35 pg | Ferritin 16–252 μg/L | ZPP <40 μmol/mol heme | sTfR 0.8–1.8 mg/L | EPO 5–26 U/L | Other |
|---|---|---|---|---|---|---|---|---|---|---|
| 1 | Storage iron depletion | 134 | 83 | 60 | 32 | 12 | 39 | 1.4 | 12 | Blood loss, hemorrhoidal bleeding |
| 2 | Iron-deficient EP | 121 | 79 | 31 | 28 | 7 | 125 | 2.1 | 9 | Hypermenorrhea |
| 3 | Iron deficiency anemia | 71 | 78 | 21 | 23 | 5 | 297 | 4.2 | 11 | Hypermenorrhea |
| 4 | Iron deficiency anemia, treated | 142 | 92 | 78 | – | 1 | 29 | 1.5 | – | 3 months Fe2+ p.o., still storage iron depletion |
| 5 | Iron deficiency anemia, hereditary | 50 | 54 | 35 | 11 | – | 1650 | – | – | Polymorphism in transferrin gene |
| 6 | ACD in Polymyalgia rheumatica | 98 | 84 | 56 | 27 | 657 | 156 | 1.2 | 11 | Hb normalization with cortisone treatment |
| 7 | ACD + iron deficiency | 76 | 75 | 42 | – | 105 | 189 | 2.5 | – | Rheumatoid arthritis |
| 8 | Vitamin B12 deficiency | 78 | 106 | 20 | 39 | 697 | 82 | 10.0 | 94 | LDH 1773 U/L Vitamin B12 32 ng/L |
| 9 | AIHA, warm-antibody | 88 | 105 | 706 | 34 | – | – | 5.5 | – | Bilirubin 5.5 mg/dL; Haptoglobin <0.07 g/L |
| 10 | AIHA, cold-antibody | 112 | 103 | 178 | 40 | 78 | 60 | 5.1 | 37 | Bilirubin 5.1 mg/dL; Haptoglobin <0.07 g/L |
| 11 | AIHA, Coombs-negative | 99 | 88 | 118 | 36 | 231 | 78 | 3.7 | 40 | Hb normalization with cortisone treatment |
| 12 | α-Thalassemia trait | 119 | 70 | 49 | 24 | 261 | 47 | 1.5 | 12 | Patient asymptomatic |
| 13 | α-Thalassemia, HbH disease | 83 | 81 | 415 | 22 | 315 | 85 | 9.0 | 97 | Bilirubin 2.4 mg/dL; LDH 690 U/L |
| 14 | β-Thalassemia major | 81 | 67 | 392 | 18 | 4311 | 105 | 13.0 | 115 | Splenectomy; polytransfused; Patient Figure 4 |
| 15 | β-Thalassemia minor | 115 | 62 | 49 | 20 | 420 | 47 | 2.1 | 15 | No transfusions |
| 16 | β-Thalassemia + iron deficiency | 132 | 65 | 49 | – | 15 | 38 | 1.89 | – | Thalassemia minor + storage iron depletion |
| 17 | PK deficiency, hereditary | 107 | 114 | 630 | 40 | 2213 | 36 | 4.0 | 21 | Splenectomy; no transfusions; bilirubin 4.8 mg/dL |
| 18 | Renal anemia | 88 | 87 | 44 | 29 | 466 | 55 | 0.47 | 8 | Creatinine 1.9 mg/dL, GFR 36 mL/min |
| 19 | Aplastic anemia | 37 | 119 | 5 | 42 | 521 | 85 | 0.48 | 6039 | Platelets 6×109/L, Leukocytes 3.4×109/L |
| 20 | Pure red cell aplasia | 51 | 94 | 6 | – | 238 | 36 | 0.28 | 1227 | Hb normalization with cortisone treatment |
| 21 | MDS, 5q- syndrome | 96 | 84 | 19 | – | 979 | 38 | 0.34 | 1788 | Polytransfused |
| 22 | MDS, 5q- syndrome | 143 | 87 | 69 | 34 | 1182 | 42 | 0.99 | 19 | Patient no. 21 with lenalidomide treatment |
| 23 | MDS, type RA | 86 | 97 | 52 | 39 | 736 | 68 | 0.81 | 70 | Results at the time of diagnosis |
| 24 | MDS, type RA | 79 | 86 | 40 | 40 | 3887 | 51 | 0.33 | 144 | Patient no. 23 after transfusion of 30 EK units |
| 25 | Multiple myeloma | 82 | 100 | 12 | – | 238 | 57 | 0.54 | – | Bone marrow: infiltration 100% |
| 26 | Acute myeloid leukemia | 68 | 88 | 7 | – | 385 | 43 | 0.18 | – | Dense bone marrow infiltration |
| 27 | NHL after high-dose chemotherapy | 79 | 85 | 6 | – | 132 | 36 | 0.29 | – | 5 days after high-dose chemotherapy |
| 28 | PMF, polytransfused | 53 | 88 | 8 | – | 1124 | 44 | 0.36 | – | Bone marrow: pronounced fibrosis |
Reference values: Lactate dehydrogenase, LDH [109–250 U/L]; Vitamin B12 [182–625 ng/L]; Bilirubin [0.1–1.2 mg/dL]; Haptoglobin [0.3–2.0 g/L]; Hb, Hemoglobin; MCV, mean corpuscular volume; Reti, reticulocytes; CHr, reticulocyte hemoglobin; EP, erythropoiesis; PK, pyruvate kinase; NHL, Non-Hodgkin lymphoma; PMF, Primary Myelofibrosis; EK, erythrocyte concentrate; GFR, glomerular filtration rate; AIHA, autoimmune hemolytic anemia.
Renal anemia deserves special mention, given its high clinical significance especially in the elderly. Renal anemia has, in fact, been described in several studies as the most frequent form of anemia in geriatric patients [9]. The loss of functional renal tissue in elderly impairs the kidney’s excretory function as well as the production of erythropoietin. When assessing on the basis of creatinine alone, the renal function of the elderly tends to be rated too positive, often resulting in a failure to recognize the renal component of the anemia. Creatinine and erythropoietin levels within the normal range do not rule out renal anemia. The creatinine is often normal as a result of reduced muscle mass, so that the assessment of the renal function should be based on a creatinine clearance instead. A Cockroft clearance is sufficient. Renal anemia can already occur at a creatinine clearance of 50 mL/min; at levels <30 mL/min, it is virtually a certainty [51, 52]. In line with the decreased erythropoiesis, the sTfR levels are in the lower reference range in the case of renal anemia. The erythropoietin level is normal or slightly elevated, but the increase is inadequate with respect to the hemoglobin concentration (Table 4).
Myelosuppression in patients after chemotherapy, or patients with bone marrow infiltration by a hematological neoplasia or carcinoma, is also very frequently associated with an anemia that generally is normochromic-normocytic. It is said to be the second most common presentation of anemia in general practice [9]. In this context, it makes sense to check first whether nucleated red cells (erythroblasts) and neutrophil precursors are released into the blood-stream. The presence of a leukoerythroblastic anemia is suggestive of a severe bone marrow damage. It is most commonly seen in association with marrow fibrosis and malignant infiltration of bone marrow, especially in patients with carcinomas of the breast, prostate gland and lung. In addition to the differential blood count, a FACS analysis of peripheral blood is required in unexplained cases in order to detect any monoclonal lymphoid population.
Practical consequences
In view of the wide array of differential diagnoses of a normochromic-normocytic anemia, it is best not to be too ambitious by trying to cover all possible causes with the first blood sample. It makes more sense to proceed step by step in the clarification and initially cover only the most important causes diagnostically. The first laboratory panel should include reticulocytes, LDH, serum creatinine, creatinine clearance, ferritin, transferrin saturation, bilirubin, ALAT and CRP. The analysis of sTfR, ZPP and erythropoietin will undoubtly facilitate the clarification. The further diagnostic procedure depends on the results obtained with the initial screening. One should not be too disappointed if the initial findings do not yield a clear result. After all, normochromic-normocytic anemias are very often not monocausal, but multifactorial, especially when it comes to older multimorbid patients. In such cases, it is not critical to identify all of the components that have contributed to the anemia. Instead, one should focus on isolating the principal cause. In addition, it is necessary to confirm or rule out all those components that can be easily treated, such as substrate or erythropoietin deficiency.
Some consider the microscopic examination of peripheral blood film an anachronism. In our view, it is the basis of every work-up of anemia that has not been clarified through a laboratory’s routine panel of tests. With regards to the immunohemolytic anemia, one should be aware that it frequently occurs in the context of a hematologic neoplasia. Arguably, these cases benefit from a referral to a hematologist. This also applies to other unexplained anemias, because in case of doubt, a bone marrow biopsy must be done to assess the hematopoiesis accurately and to reliably rule out an underlying hematological disorder.
Acknowledgments:
The authors thank Prof. G. Löffler for critically reading the manuscript.
Author contributions: All the authors have accepted responsibility for the entire content of this submitted manuscript and approved submission.
Research funding: None declared.
Employment or leadership: None declared.
Honorarium: None declared.
Competing interests: The funding organization(s) played no role in the study design; in the collection, analysis, and interpretation of data; in the writing of the report; or in the decision to submit the report for publication.
References
1. World health organisation. Nutritional anemia: report of a WHO scientific group. Geneva, Switzerland: WHO Press, 1968.Suche in Google Scholar
2. Kassebaum NJ, Jasrasaria R, Naghavi M, Wulf SK, Johns N, Lozano R, et al. A systematic analysis of global anemia burden from 1990 to 2010. Blood 2014;123:615–24.10.1182/blood-2013-06-508325Suche in Google Scholar PubMed PubMed Central
3. Shander A, Goodnough LT, Javidroozi M, Auerbach M, Carson J, Ershler WB, et al. Iron deficiency anemia–bridging the knowledge and practice gap. Transfu Med Rev 2014;28:156–66.10.1016/j.tmrv.2014.05.001Suche in Google Scholar PubMed
4. Kohne E. Hemoglobinopathies: clinical manifestations, diagnosis, and treatment. Deut Arzteblatt Int 2011;108:532–40.10.3238/arztebl.2011.0532Suche in Google Scholar
5. Eber S, Dickerhoff R. Anemia and hemoglobin diseases in patients with migration background. Deut Med Wochenschr 2014;139:434–40.10.1055/s-0034-1369813Suche in Google Scholar
6. Joosten E, Lioen P. Iron deficiency anemia and anemia of chronic disease in geriatric hospitalized patients: how frequent are comorbidities as an additional explanation for the anemia? Geriatr Gerontol Int 2014;15:931–5.10.1111/ggi.12371Suche in Google Scholar PubMed
7. Guralnik JM, Eisenstaedt RS, Ferrucci L, Klein HG, Woodman RC. Prevalence of anemia in persons 65 years and older in the United States: evidence for a high rate of unexplained anemia. Blood 2004;104:2263–8.10.1182/blood-2004-05-1812Suche in Google Scholar PubMed
8. Guralnik JM, Ershler WB, Schrier SL, Picozzi VJ. Anemia in the elderly: a public health crisis in hematology. Hematology Am Soc Hematol Educ Program 2005:528–32.10.1182/asheducation-2005.1.528Suche in Google Scholar PubMed
9. Merlo Ch M, Wuillemin WA. Prevalence and causes of anemia in a city general practice. Praxis 2008;97:713–8.10.1024/1661-8157.97.13.713Suche in Google Scholar
10. Migone De Amicis M, Poggiali E, Motta I, Minonzio F, Fabio G, Hu C, et al. Anemia in elderly hospitalized patients: prevalence and clinical impact. Int Emergen Med 2015;10:581–6.10.1007/s11739-015-1197-5Suche in Google Scholar PubMed
11. Tettamanti M, Lucca U, Gandini F, Recchia A, Mosconi P, Apolone G, et al. Prevalence, incidence and types of mild anemia in the elderly: the “Health and Anemia” populationbased study. Haematologica 2010;95:1849–56.10.3324/haematol.2010.023101Suche in Google Scholar PubMed PubMed Central
12. Hastka J, Lasserre JJ, Schwarzbeck A, Reiter A, Hehlmann R. Laboratory tests of iron status: correlation or common sense? Clin Chem 1996;42:718–24.10.1093/clinchem/42.5.718Suche in Google Scholar
13. Metzgeroth G, Hastka J. Diagnostic work-up of iron deficiency Laboratoriums Medizin 2004;28:391–9.10.1515/LabMed.2004.054Suche in Google Scholar
14. World health organisation, centers for disease control and prevention. Assessing the iron status of population. Geneva, Switzerland: WHO Press, 2004.Suche in Google Scholar
15. Suominen P, Punnonen K, Rajamaki A, Irjala K. Serum transferrin receptor and transferrin receptor-ferritin index identify healthy subjects with subclinical iron deficits. Blood 1998;92:2934–9.10.1182/blood.V92.8.2934.420k07_2934_2939Suche in Google Scholar
16. Cankurtaran M, Yavuz B, Halil M, Ulger Z, Haznedaroglu I, Ariogul S. Increased ferritin levels are critical due to ageassociated inflammation and may obscure underlying iron deficiency in the geriatric population. Eur Geriatr Med 2012;3:277–80.10.1016/j.eurger.2012.06.005Suche in Google Scholar
17. World health organisation, centers for disease control and prevention. Assessing the iron status of population: Geneva, Switzerland: WHO Press, 2007.Suche in Google Scholar
18. Thurnham DI, McCabe LD, Haldar S, Wieringa FT, Northrop-Clewes CA, McCabe GP. Adjusting plasma ferritin concentrations to remove the effects of subclinical inflammation in the assessment of iron deficiency: a meta-analysis. Am J Clin Nutr 2010;92:546–55.10.3945/ajcn.2010.29284Suche in Google Scholar PubMed
19. Labbe RF, Finch CA, Smith NJ, Doan RN, Sood SK, Madan N. Erythrocyte protoporphyrin/heme ratio in the assessment of iron status. Clin Chem 1979;25:87–92.10.1093/clinchem/25.1.87Suche in Google Scholar
20. Lamola AA, Eisinger J, Blumberg WE. Erythrocyte protoporphyrin/heme ratio by hematofluorometry. Clin Chem 1980;26:677–8.10.1093/clinchem/26.5.677Suche in Google Scholar
21. Kohgo Y, Niitsu Y, Condo H, Kato J, Tsushima N, Sasaki K, et al. Serum transferrin receptor as a new index of erythropoiesis. Blood 1987;70:1955–8.10.1182/blood.V70.6.1955.1955Suche in Google Scholar
22. Metzgeroth G, Schultheis B, Kuhn C, Dorn-Beineke A, LaRosee P, Hehlmann R, et al. The soluble transferrin receptor reflects tumor load in chronic lymphocytic leukemia. Clin Chem Lab Med 2007;45:1313–8.10.1515/CCLM.2007.287Suche in Google Scholar PubMed
23. Thomas C, Thomas L. Biochemical markers and hematologic indices in the diagnosis of functional iron deficiency. Clin Chem 2002;48:1066–76.10.1093/clinchem/48.7.1066Suche in Google Scholar
24. Punnonen K, Irjala K, Rajamaki A. Serum transferrin receptor and its ratio to serum ferritin in the diagnosis of iron deficiency. Blood 1997;89:1052–7.10.1182/blood.V89.3.1052Suche in Google Scholar
25. Weiss G, Goodnough LT. Anemia of chronic disease. New Engl J Med 2005;352:1011–23.10.1056/NEJMra041809Suche in Google Scholar PubMed
26. Cartwright GE, Lee GR. The anaemia of chronic disorders. Br J Haematol 1971;21:147–52.10.1111/j.1365-2141.1971.tb03424.xSuche in Google Scholar PubMed
27. Weiss G. Iron metabolism in the anemia of chronic disease. Biochim Bioph acta 2009;1790:682–93.10.1016/j.bbagen.2008.08.006Suche in Google Scholar PubMed
28. Hastka J, Lasserre JJ, Schwarzbeck A, Strauch M, Hehlmann R. Zinc protoporphyrin in anemia of chronic disorders. Blood 1993;81:1200–4.10.1182/blood.V81.5.1200.1200Suche in Google Scholar
29. Ferguson BJ, Skikne BS, Simpson KM, Baynes RD, Cook JD. Serum transferrin receptor distinguishes the anemia of chronic disease from iron deficiency anemia. J Lab Clin Med 1992;119:385–90.Suche in Google Scholar
30. Skikne B, Flowers CH, Cook JD. Serum transferrin receptor: a quantitative measure of tissue iron deficiency. Blood 1990;75:1870–6.10.1182/blood.V75.9.1870.1870Suche in Google Scholar
31. Nemeth E. Hepcidin biology and therapeutic applications. Expert Rev Hematol 2010;3:153–5.10.1586/ehm.10.1Suche in Google Scholar PubMed
32. Kemna EH, Tjalsma H, Willems HL, Swinkels DW. Hepcidin: from discovery to differential diagnosis. Haematologica 2008;93: 90–7.10.3324/haematol.11705Suche in Google Scholar PubMed
33. D’Angelo G. Role of hepcidin in the pathophysiology and diagnosis of anemia. Blood Res 2013;48:10–5.10.5045/br.2013.48.1.10Suche in Google Scholar PubMed PubMed Central
34. Metzgeroth G, Kripp M, Muller N, Schultheis B, Bonatz K, Walz C, et al. The soluble transferrin receptor (TfR)-F-Index is not applicable as a test for iron status in patients with chronic lymphocytic leukemia. Clin Chem Lab Med 2009;47: 1291–5.10.1515/CCLM.2009.273Suche in Google Scholar PubMed
35. Whitehead VM. Acquired and inherited disorders of cobalamin and folate in children. Br J Haematol 2006;134:125–36.10.1111/j.1365-2141.2006.06133.xSuche in Google Scholar PubMed
36. Hoffbrand AV, Weir DG. The history of folic acid. Br J Haematol 2001;113:579–89.10.1046/j.1365-2141.2001.02822.xSuche in Google Scholar PubMed
37. Stabler SP. Vitamin B12 deficiency. N Engl J Med 2013;368:2041–2.10.1056/NEJMcp1113996Suche in Google Scholar PubMed
38. Quadros EV. Advances in the understanding of cobalamin assimilation and metabolism. Br J Haematol 2010;148:195–204.10.1111/j.1365-2141.2009.07937.xSuche in Google Scholar
39. Allen LH. Causes of vitamin B12 and folate deficiency. Food Nutr Bull 2008;29(2 Suppl):S20–34; discussion S5–7.10.1177/15648265080292S105Suche in Google Scholar
40. Carmel R, Green R, Rosenblatt DS, Watkins D. Update on cobalamin, folate, and homocysteine. Hematology Am Soc Hematol Educ Program 2003;1:62–81.10.1182/asheducation-2003.1.62Suche in Google Scholar
41. Nexo E, Hoffmann-Lücke E. Holotranscobalamin, a marker of vitamin B-12 status: analytical aspects and clinical utility. Am J Clin Nutr 2011;94:3595.10.3945/ajcn.111.013458Suche in Google Scholar
42. Malcovati L, Hellstrom-Lindberg E, Bowen D, Ades L, Cermak J, Del Canizo C, et al. Diagnosis and treatment of primary myelodysplastic syndromes in adults: recommendations from the European LeukemiaNet. Blood 2013;122:2943–64.10.1182/blood-2013-03-492884Suche in Google Scholar
43. Scully M. Trends in the diagnosis and management of TTP: European perspective. Transfus Apher Sci 2014;51:11–4.10.1016/j.transci.2014.08.001Suche in Google Scholar
44. Tarr PI, Gordon CA, Chandler WL. Shiga-toxin-producing Escherichia coli and haemolytic uraemic syndrome. Lancet 2005;365:1073–86.10.1016/S0140-6736(05)71144-2Suche in Google Scholar
45. Levy GG, Nichols WC, Lian EC, Foroud T, McClintick JN, McGee BM, et al. Mutations in a member of the ADAMTS gene family cause thrombotic thrombocytopenic purpura. Nature 2001;413:488–94.10.1038/35097008Suche in Google Scholar PubMed
46. Dacie SJ. The immune haemolytic anaemias: a century of exciting progress in understanding. Br J Haematol 2001;114:770–85.10.1046/j.1365-2141.2001.02945.xSuche in Google Scholar PubMed
47. Segel GB, Lichtman MA. Direct antiglobulin (“Coombs”) testnegative autoimmune hemolytic anemia: a review. Blood Cell Mol Dis 2014;52:152–60.10.1016/j.bcmd.2013.12.003Suche in Google Scholar PubMed
48. Hochsmann B, Rojewski M, Schrezenmeier H. Paroxysmal nocturnal hemoglobinuria (PNH): higher sensitivity and validity in diagnosis and serial monitoring by flow cytometric analysis of reticulocytes. Ann Hematol 2011;90:887–99.10.1007/s00277-011-1177-4Suche in Google Scholar PubMed PubMed Central
49. Nebe T, Schubert J, Gutensohn K, Schrezenmeier H. Flow cytometric analysis of GPI-deficient cells for the diagnosis of paroxysmal nocturnal hemoglobinuria. Laboratoriums Medizin 2003;27:257–65.10.1515/LabMed.2003.038Suche in Google Scholar
50. Metzgeroth G, Adelberger V, Dorn-Beineke A, Kuhn C, Schatz M, Maywald O, et al. Soluble transferrin receptor and zinc protoporphyrin–competitors or efficient partners? Eur J Haematol 2005;75:309–17.10.1111/j.1600-0609.2005.00515.xSuche in Google Scholar PubMed
51. Hsu CY, Bates DW, Kuperman GJ, Curhan GC. Relationship between hematocrit and renal function in men and women. Kidney Int 2001;59:725–31.10.1046/j.1523-1755.2001.059002725.xSuche in Google Scholar PubMed
52. Ble A, Fink JC, Woodman RC, Klausner MA, Windham BG, Guralnik JM, et al. Renal function, erythropoietin, and anemia of older persons: the InCHIANTI study. Arch Int Med 2005;165:2222–7.10.1001/archinte.165.19.2222Suche in Google Scholar PubMed
Article note:
Original German online version at: http://www.degruyter.com/view/j/labm.2015.39.issue-5/labmed-2015-0053/labmed-2015-0053.xml?format=INT. The German article was translated by Compuscript Ltd. and authorized by the authors.
©2016 by De Gruyter
This article is distributed under the terms of the Creative Commons Attribution Non-Commercial License, which permits unrestricted non-commercial use, distribution, and reproduction in any medium, provided the original work is properly cited.
Artikel in diesem Heft
- The influence of the trace element zinc on the immune system
- Lipoprotein(a): when to measure, how to treat?
- Diagnostics and importance of hepatitis E virus infections
- Hemoglobin variants – pathomechanism, symptoms and diagnosis
- In-vitro allergy diagnostics
- Diagnostics of myelodysplastic syndromes (MDS) and acute myeloid leukemia (AML)
- A systematic approach to billing laboratory services – the legal framework: Supplement and update to the article in J Lab Med 2014; 38(4):179–205
- Diagnostic relevance of CSF interleukin-6
- Stepwise diagnostic procedure for the analysis of pathological changes of leukocytes
- Simple estimation of reference intervals from routine laboratory data
- Rational diagnostic work-up of anemia
- Quality assurance in the analysis of growth hormone and insulin-like growth factor I in disorders of the somatotropic axis
- Stepwise diagnostics of hemoglobinopathies
Artikel in diesem Heft
- The influence of the trace element zinc on the immune system
- Lipoprotein(a): when to measure, how to treat?
- Diagnostics and importance of hepatitis E virus infections
- Hemoglobin variants – pathomechanism, symptoms and diagnosis
- In-vitro allergy diagnostics
- Diagnostics of myelodysplastic syndromes (MDS) and acute myeloid leukemia (AML)
- A systematic approach to billing laboratory services – the legal framework: Supplement and update to the article in J Lab Med 2014; 38(4):179–205
- Diagnostic relevance of CSF interleukin-6
- Stepwise diagnostic procedure for the analysis of pathological changes of leukocytes
- Simple estimation of reference intervals from routine laboratory data
- Rational diagnostic work-up of anemia
- Quality assurance in the analysis of growth hormone and insulin-like growth factor I in disorders of the somatotropic axis
- Stepwise diagnostics of hemoglobinopathies